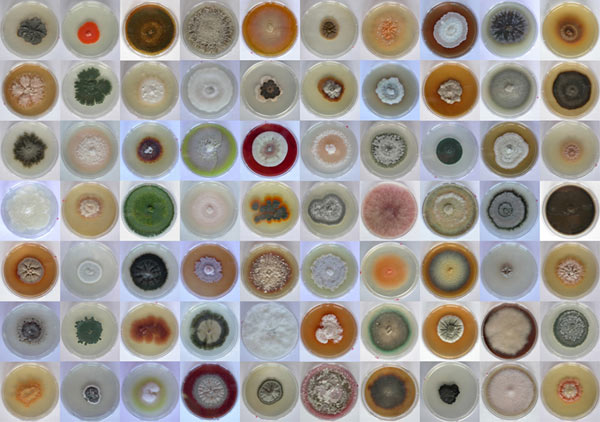

Otros mundos
by , 26/03/10 at 01:14:55 (5970 Visitas)
Puede que cuando penséis en "fotografía científica" os sugiera algo aburrido, limitado a los laboratorios y difícil de entender: fotografías de bacterias, microorganismos sin embargo, es mucho más, y aunque hay partes para las que necesitamos material muy específico, la fotografía científica es mucho más amplia y abarca también otros campos (por ejemplo, la fotografía de fauna y flora), ¡Pasando incluso por las radiografías!
Todos estaremos de acuerdo en que la fotografía es el método más exacto y rápido para representar cosas, seres vivos o fenómenos, por la inmediatez y precisión, y por que nos permite técnicamente jugar con focales, grandes aproximaciones (a lo que está muy lejos o a lo que es tremendamente pequeño), velocidades muy altas, o representando cosas que sólo son visibles en longitudes de onda que no abarca el ojo humano.
De esta manera, el punto en común de todas las temáticas que abarca la fotografía científica es que se utilizan para el estudio o la investigación, por lo que supone una parte importante para el campo científico.
Es por esto que se convoca cada año un concurso que premia a las mejores fotografías científicas. Veamos los ganadores de la última edición:
Primer Premio en la categoría General
Título: Endofitos
Autor: Dª. Maria Salud Sánchez Márquez
Coautor: D. Iñigo Zabalgogeazcoa
Accésit categoría General
Título: Gran Telescopio Canarias
Autor: D. Xavier Patiño Vidal
Primer premio categoría Micro
Título: Revuelto de champiñones
Autor: D. José Luis Prieto Martín
Accésit categoría Micro
Título: Nos gusta viajar
Autor: D. Jesús Yániz Pérez de Albéniz
Premio especial Año Internacional la Biodiversidad 2010
Título: Canto de sirenas
Autor: Autor: D. Nicolás Sánchez-Biedma
Premio especial Año Internacional del Acercamiento de las Culturas 2010
Título: Terrazas solares de Banaue
Autor: Eberhardt Josue Friedrich Kernahan
Premio votación popular categoría Micro
Título: Sobrevolando el intestino
Autor: Dª. María Vicario Pérez
Premio votación popular categoría General
Título: Sumideros de radiación
Autor: D. Pablo Zarco Tejada
Coautores: J.A.J. Berni, I. Moorthy, M.L. Guillén, L. Suárez, J.R. Miller
Vemos desde perspectivas curiosas hasta bonitas composiciones y colores, destacando los paisajes inimaginables, o muestras de malabarismos a "micro-escala", con esa especie de champiñones que crean una estructura imposible de ser de un tamaño "palpable". En realidad se necesita una gran creatividad e imaginación para conseguir cualquiera de estas tomas, que resultan muy interesantes pese a no aportar carga emotiva o personal.
Todo un mundo (o un montón de ellos) por descubrir.